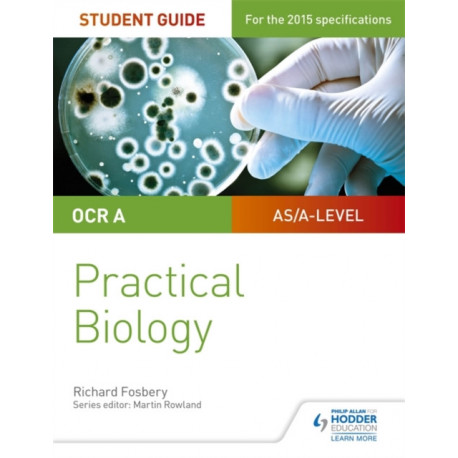
OCR A-level Biology Student Guide: Practical Biology

Kurv
Vare
varer
(tom)
Ingen varer
Fastlægges senere
Forsendelse
0,- kr
I alt
OCR A-level Biology Student Guide: Practical Biology
(Bog, Paperback / softback, Engelsk)
Forlag:
Hachette Learning
- Type: Bog
- Format: Paperback / softback
-
Sprog:
Engelsk

- ISBN-13: 9781471885617
- Se flere detaljer ▼
Bemærk: Kan ikke leveres før jul.
Beskrivelse
Ensure your students get to grips with the core practicals and develop the skills needed to succeed with an in-depth assessment-driven approach that builds and reinforces understanding; clear summaries of practical work with sample questions and answers help to improve exam technique in order to achieve higher grades.
Læsernes anmeldelser (0)
Alle detaljer
| Forlag | Hachette Learning |
| Forfatter | Richard Fosbery |
| Type | Bog |
| Format | Paperback / softback |
| Sprog | Engelsk |
| Udgivelsesdato | 28-04-2017 |
| Første udgivelsesår | 2017 |
| Originalsprog | United Kingdom |
| Sideantal | 104 |
| Indbinding | Paperback / softback |
| Forlag | Hachette Learning |
| Sideoplysninger | 104 pages |
| Mål | 247 x 190 x 6 |
| ISBN-13 / EAN-13 | 9781471885617 |

